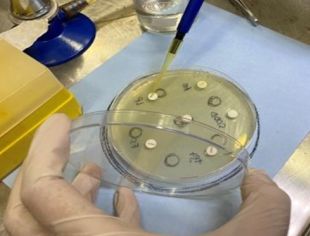
yerba mate bacterias

Comprueban actividad antimicrobiana de extractos acuosos de yerba mate
Con el aumento de la resistencia a los antimicrobianos, a nivel mundial hay un renovado interés en los productos naturales como alternativas efectivas, por lo cual se viene explorando y valorando el uso de los productos naturales como fuente de nuevos y variados agentes antimicrobianos.
La yerba mate (Ilex paraguariensis) es una planta originaria de Sudamérica ampliamente consumida como infusión, y en las últimas décadas ha sido objeto de estudio debido a sus propiedades antimicrobianas.
Distintos componentes de la yerba mate han mostrado actividad contra algunas bacterias patógenas, por lo cual el Laboratorio de Bioquímica Aplicada, de la Facultad de Ciencias Exactas y Naturales y Agrimensura (FaCENA), puso en marcha un proyecto para evaluar la actividad antimicrobiana de los extractos acuosos de yerba mate frente a microorganismos patógenos.
Al respecto, de manera reciente, presentaron avances del proyecto, con resultados que mostraron que extractos exhibieron actividad antimicrobiana significativa contra la cepa Staphilococo aureus, una cepa patógena que puede producir una amplia gama de enfermedades.
«Los resultados obtenidos indican que la yerba mate podría ser una alternativa viable para desarrollar nuevos agentes antimicrobianos naturales aplicables en la industria alimentaria y médica, contribuyendo así a la búsqueda de soluciones frente a la resistencia antimicrobiana» destacan desde el equipo de investigación conformado por la Bioq. Natalia Serrano, Bioq. Angélica Macarena Cesario, Bioq. Patricia Goicoechea y el Dr. Marcos Maiocchi.
En el marco de la continuidad del estudio, el objetivo es poder identificar la capacidad inhibitoria de los extractos acuosos de yerba mate frente a otros patógenos, así como en optimizar las técnicas de detección del poder inhibitorio de los extractos.
Detalles del Trabajo
En el marco de los ensayos, para la obtención del extractos acuosos de yerba mate, se preparó una infusión y los extractos obtenidos se liofilizaron y se almacenaron a -20ºC hasta el momento de realizar los ensayos.
Como no existe reglamentación y/o estandarización de la metodología para evaluar la capacidad inhibitoria del desarrollo microbiano de extractos vegetales, se recurrió a la implementación de técnicas similares a las empleadas en la evaluación de la sensibilidad de los microorganismos a los antibióticos.
Así, en el estudio se realizaron ensayos denominados «de bioautografía» y de «difusión por discos» para la obtención de resultados cualitativos y, para resultados cuantitativos se experimentó con la técnica de determinación de la Concentración Inhibitoria Mínima (CIM).
De acuerdo a los resultados, la técnica de bioautografía permitió identificar compuestos activos dentro de los extractos, aunque se encontraron dificultades para observar zonas de inhibición debido a la coloración de los extractos utilizados.
En tanto, los resultados de la técnica de difusión a través de discos, mostraron que varios extractos exhibieron actividad antimicrobiana significativa, evidenciada por la formación de halos de inhibición en las placas de cultivo, así como por la reducción en el crecimiento bacteriano en los ensayos de dilución dependiente de la dosis con la cepa S. aureus.
Relevancia
«El estudio comprobó la capacidad antimicrobiana de los extractos de yerba frente a una cepa, pero abre las puertas para seguir estudiando esta propiedad para inhibir a otras bacterias de relevancia», destacó en diálogo con UNNE Medios la Bioq. Natalia Serrano, codirectora del proyecto.
Señaló que además se logró corroborar qué técnicas convencionales son las más apropiadas para validar la eficacia antimicrobiana.
En esa línea, comentó que se proyecta seguir trabajando en pos de lograr la optimización de las técnicas utilizadas e incluso el ajuste de nuevas técnicas experimentales.
Respecto a la relevancia de la búsqueda de productos naturales como fuente de agentes antimicrobianos, indicó que la Organización Mundial de la Salud (OMS) reconoce la importancia de las plantas medicinales en el tratamiento y prevención de enfermedades, así como también a nivel económico, al ser una fuente de descubrimiento de nuevas drogas que, en algunos casos, tienen un costo muy inferior a la síntesis de nuevos fármacos.
Grupo de Investigación
La Bioq. Serrano detalló que la investigación realizada se enmarca en un proyecto mayor denominado “Estudios físico-químicos y nutricionales para la caracterización y el control de calidad de materias primas, alimentos y subproductos de la región NEA”.
Justamente, como parte de esa línea integral de investigación, es que en la reciente edición de las «Jornadas Anuales de la Sociedad Argentina de Biología» presentó el artículo «Estudio de la actividad antimicrobiana de extractos acuosos de yerba mate (Ilex paraguariensis)».
En las mencionadas jornadas de la SAB, se presentó además el trabajo «Evaluación del efecto de extractos acuosos de yerba mate (Ilex paraguariensis) sobre células tumorales mamarias murinas» a cargo en este caso del Grupo de Investigaciones Biológicas y Moleculares, UNNE y Conicet.










